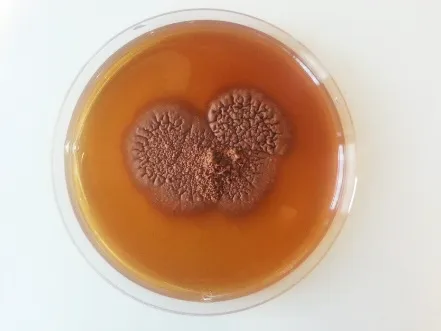

الوَرَم الفُطْرِيّ: تدريب العاملين الصحيين على المستوى الوطني ومستوى المناطق حول أمراض المناطق المدارية المهملة التي تُصيب الجلد
- إدراك الخصائص الوبائية للوَرَم الفُطْرِيّ؛
- وصف الجوانب السريريةللمرض؛
- إدراك كيفية إجراء التشخيص؛
- توضيح كيفية علاج الوَرَمالفُطْرِيّ؛
- وصف تدخلات الصحة العامة.
إن الوَرَم الفُطْرِيّ هو مرضٌ معديٌ مزمنٌ يدمر تدريجيًا الأنسجة تحت الجلد، ويؤذي الجلد والعضلات والعظام. ويحدث الوَرَم الفُطْرِيّ في البيئات المدارية وشبه المدارية التي تتصف بمواسم ممطرة قصيرة ومواسم جافة طويلة تدعم نمو الشجيرات الشائكة. ولا يزال العبء العالمي للمرض غير معروف، إلا أنه مرضٌ متوطنٌ؛ ويُبلغ عنه من بلدان في أفريقيا وآسيا وأوروبا وأمريكا اللاتينية. وتتناول هذه الدورة التدريبية الخصائص الوبائية للوَرَم الفُطْرِيّ، وأعراضه السريرية، وتشخيصه، وعلاجه، والتدخلات الصحية العامة بشأنه.
لمحة عامة: يُعتبر الوَرَم الفُطْرِيّ مرضًا مزمنًا يصيب عادةً القدم، ولكنه قد يصيب أيضًا أي جزءٍ آخر من أجزاء الجسم. وتُكتسب العدوى به غالبًا عن طريق التلقيح الرضحي لأنواع معينة من الفطريات أو الجراثيم في الأنسجة الموجودة تحت الجلد. ويصيب المرض عادةً البالغين الشباب، ومعظمهم من الذكور الذين تتراوح أعمارهم بين 15 إلى 30 عامًا في البلدان النامية. وأكثر المتضررين هم الأشخاص ذوو الوضع الاجتماعي والاقتصادي المنخفض والعمال اليدويون مثل المزارعين والعمال والرعاة.
ويتسبب الوَرَم الفُطْرِيّ في العديد من الآثار الضارة طبيًا وصحيًا واجتماعيًا واقتصاديًا للمرضى والمجتمعات والسلطات الصحية. ولا تتوافر بيانات دقيقة حول معدل الإصابة بالمرض ومعدل انتشاره. ومع ذلك، يُعتبر الكشف والعلاج المبكران مُهمين للحد من المراضة وتحسين حصائل العلاج.
ويتمثل الهدف من هذه الدورة التدريبية في تقديم معلومات عن الوَرَم الفُطْرِيّ لزيادة معارف ومهارات العاملين الصحيين على المستوى الوطني وفي الخطوط الأمامية للتصدي لهذا المرض.
مدة الدورة التقريبية: مدة الدورة: حوالي 30 دقيقة.
اللغات
هذه الدورة متاحة باللغات التالية: Bahasa Indonesia, 中文, English, español
تمت ترجمة هذه الدورة إلى اللغة العربية. منظمة الصحة العالمية ليست مسؤولة عن محتوى أو دقة هذه الترجمة. في حالة وجود اختلافات بين النسخة الإنجليزية وترجمتها، تسود النسخة الإنجليزية الأصلية وسيتم النظر في النسخة الأصلية.
تحذير بشأن المحتوى: قد تحتوي هذه الدورة على صور ومقاطع فيديو ومواد وسائط متعددة تتعلق بالرعاية الصحية والتي قد تتضمن تصويرًا بيانيًا للحالات الطبية والإجراءات الجراحية والمحتويات السريرية الأخرى. هذه المواد مخصصة للأغراض التعليمية لتعزيز فهم السيناريوهات الطبية في العالم الحقيقي وهي ضرورية لتجربة التعلم الشاملة.
يُنصح بتقدير المشاهد. إذا وجدت أي محتوى مزعجًا، فيمكنك إيقاف المواد مؤقتًا أو تخطيها حسب الحاجة.
Assessment & Awards
سوف تتلقى تأكيد المشاركة عند الانتهاء من جميع الوحدات في هذه الدورة. يرجى ملاحظة أن هذه الجائزة لا تعمل كمؤهل مهني.
العاملون الصحيون على المستوى الوطني وفي الخطوط الأمامية
مذكرة إرشادية
تم التحقق من صحة محتوى هذه الدورة التدريبية والتحقق منها وهي مملوكة للكيان التالي: WHO Neglected Tropical Diseases team.
هذه الدورة ليست دورة تم إنتاجها بشكل مشترك من قبل أكاديمية منظمة الصحة العالمية. في حالة وجود أي مخاوف أو ملاحظات حول محتوى الدورة، يرجى مشاركة ملاحظاتك في نموذج الاستبيان في نهاية هذه الدورة.
توافق المتصفح والجهاز
للحصول على أفضل تجربة، نوصي باستخدام أحدث إصدار من Chrome أو Firefox أو Safari أو Microsoft Edge للوصول إلى الدورات التدريبية.
من إنتاج: WHO Neglected Tropical Diseases team.

